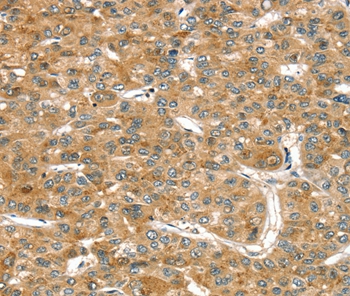

RASSF9 / P-CIP1 Antibody (aa362-411)
LS-C170438
ApplicationsWestern Blot
Product group Antibodies
TargetRASSF9
Overview
- SupplierLifeSpan BioSciences
- Product NameRASSF9 / P-CIP1 Antibody (aa362-411)
- Delivery Days Customer14
- ApplicationsWestern Blot
- Applications SupplierWB
- CertificationResearch Use Only
- ClonalityPolyclonal
- Concentration0.5 mg/ml
- ConjugateUnconjugated
- Estimated Purity...
- Gene ID9182
- Target nameRASSF9
- Target descriptionRas association domain family member 9
- Target synonymsPAM COOH-terminal interactor protein 1; PAMCI; PCIP1; P-CIP1; peptidylglycine alpha-amidating monooxygenase COOH-terminal interactor protein-1; Ras association (RalGDS/AF-6) domain family (N-terminal) member 9; ras association domain-containing protein 9
- HostRabbit
- Storage Instruction-20°C,2°C to 8°C
- UNSPSC12352203